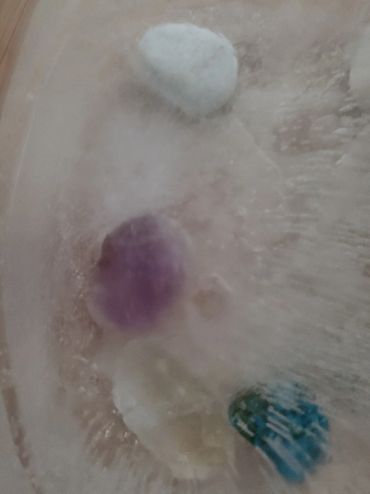

In my life, I wanted to be three things. A teacher, writer, and geologist. I suppose two out of three isn't bad, but it hasn't stopped my love for everything geological, including the history and beauty of rocks. Yes, rocks, not just the gold shiny ones, are beautiful.
I have added my videos I created on an old YouTube Channel, to my regular YouTube Channel, with the Playlist called, what else, "The RockNerd"
Yes, rocks. Definitely. I collect all types of rocks, crystals, minerals, and everything in between. I also create handmade rock sculptures (I use craft rocks for these, where I come up with my own paint colors for the rocks, and build something.)

We use cookies to analyze website traffic and optimize your website experience. By accepting our use of cookies, your data will be aggregated with all other user data.

Kindness is not weakness.
It’s the strength to listen when others turn away.
It’s the courage to speak gently in a loud world.
It’s the choice to see worth in every soul—especially our own.
I created this campaign because I’ve been dismissed.
But kindness refuses to be silent.
Join me. Wear it. Share it. Live it.
Be kind. Always.